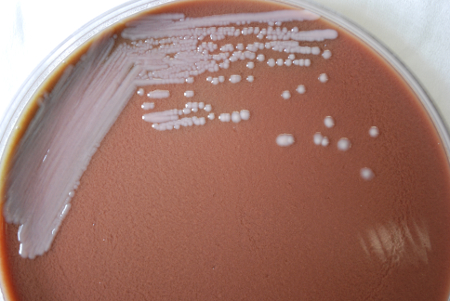

Images and videos
Images

Melioidosis and glanders
Colonial morphology displayed by gram-negative Burkholderia pseudomallei bacteria (melioidosis), grown on a medium of chocolate agar, for a 72-hour time period, at a temperature of 37°C
CDC Public Health Image Library (PHIL)
See this image in context in the following section/s:

Melioidosis and glanders
Endemicity of melioidosis infection
CDC
See this image in context in the following section/s:
Melioidosis and glanders
Colonial morphology displayed by gram-negative Burkholderia mallei bacteria (glanders), grown on a medium of chocolate agar, for a 72-hour time period, at a temperature of 37°C
CDC Public Health Image Library (PHIL)
See this image in context in the following section/s:
Use of this content is subject to our disclaimer


